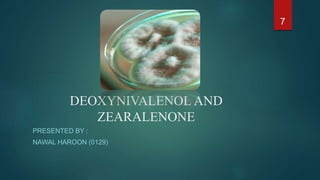
Mycotoxins types and characterization

Embed presentation
Download to read offline








































This document is a presentation on mycotoxins submitted by Group 3 for their Food Chemistry course. It contains sections on various mycotoxins including deoxynivalenol and zearalenone presented by Nawal Haroon, aflatoxins presented by Zakia Akram, and ochratoxin presented by Wajeeha Batool. The presentations define the mycotoxins, discuss where they are commonly found and the fungi that produce them, their history, effects on health, and methods of detection and prevention.